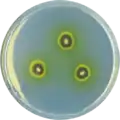
Aspergillus astellatus growing on CYA plate

Aspergillus astellatus
| Aspergillus astellatus | |
|---|---|
| Scientific classification | |
| Kingdom: | Fungi |
| Division: | Ascomycota |
| Class: | Eurotiomycetes |
| Order: | Eurotiales |
| Family: | Aspergillaceae |
| Genus: | Aspergillus |
| Species: | A. astellatus
|
| Binomial name | |
| Aspergillus astellatus (Fennell & Raper) Houbraken, Visagie & Samson 2014[1]
| |
| Type strain | |
| CBS 134.55, CBS 261.93, NRRL 2396, WB 2396 = CBS 134.55 = IBT 22589[2] | |
| Synonyms | |
|
Aspergillus variecolor var. astellatus,[2] | |
Aspergillus astellatus is a species of the genus of Aspergillus.[1][2] It is from the Nidulantes section.[3] Aspergillus astellatus produces Aflatoxin B1, Aflatoxin B2 and sterigmatocystin.[4][5]
Growth and morphology
A. astellatus has been cultivated on both Czapek yeast extract agar (CYA) plates and Malt Extract Agar Oxoid (MEAOX) plates. The growth morphology of the colonies can be seen in the pictures below.
-
Aspergillus astellatus growing on CYA plate
Aspergillus astellatus growing on CYA plate -
 Aspergillus astellatus growing on MEAOX plate
Aspergillus astellatus growing on MEAOX plate
References
- ^ a b c Samson R.A.; Visagie, C.M.; Houbraken, J.; Hong, S-B.; Hubka, V.; Klaassen C.H.W.; Perrone, G.; Seifert, K.; Susca, A.; Tanney, J.B.; Varga, J.; Kocsube, S.; Szigeti, G.; Yaguchi, T.; Frisvad, J.C. 2014. Phylogeny, identification and nomenclature of the genus Aspergillus. Studies in Mycology. 78:141-173
- ^ a b c d "Aspergillus astellatus". www.uniprot.org.
- ^ Chen, A.J.; Frisvad, J.C.; Sun, B.D.; Varga, S.; Kocsubé, S.; Dijksterhuis, J.; Kim, D.H.; Hong, S.-B.; Houbraken, J.; Samson, R.A. (2016). "Aspergillus section Nidulantes (formerly Emericella): Polyphasic taxonomy, chemistry and biology". Studies in Mycology. 84: 1–118. doi:10.1016/j.simyco.2016.10.001. PMC 5198626. PMID 28050053.
- ^ R., Russell; M., Paterson; Nelson, Lima (2015). Molecular Biology of Food and Water Borne Mycotoxigenic and Mycotic Fungi. CRC Press. ISBN 978-1-466-55988-2.
- ^ Frisvad, J.C.; Samson, R.A.; Smedsgaard, J. (May 2004). "Emericella astellata, a new producer of aflatoxin B1, B2 and sterigmatocystin". Letters in Applied Microbiology. 38 (5): 440–445. doi:10.1111/j.1472-765X.2004.01520.x. PMID 15059218. S2CID 25178190.
Further reading
- Leslie, John F.; Logrieco, Antonio, eds. (2014). Mycotoxin reduction in grain chaings. Stafford BC, Qld.: Wiley-Blackwell. ISBN 978-0-813-82083-5.